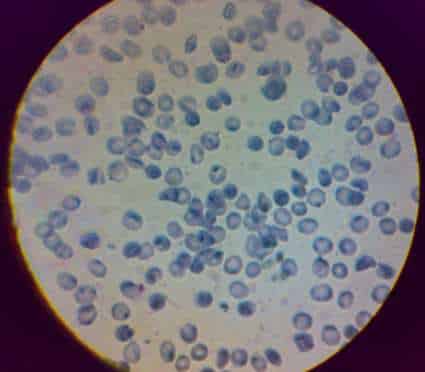
CellScope

Povia e il concerto annullato: ‘etichettato come cantante di destra’
Musica: il cantante Povia polemico con l’estremizzazione: ‘il mio concerto è stato annullato, perchè etichettato come cantante di destra’ Il ...
Musica: il cantante Povia polemico con l’estremizzazione: ‘il mio concerto è stato annullato, perchè etichettato come cantante di destra’ Il ...
Un sondaggio ha evidenziato ancora una volta, quello che purtroppo già da qualche anno era venuto alla luce: La Gen ...
Un ritrovamento ha scosso il mondo dell’archeologia: scoperto il segreto della ‘Mummia urlante’ Nel 1935, una spedizione archeologica a Deir ...
Il caffè può essere un alleato quotidiano per il benessere fisico dell’intestino, selezionando i batteri buoni del microbiota, ma come? ...
Carceri, il trend è allucinante. dal 2014 a oggi sono stati oltre 600 i suicidi e si rischia un triste ...
Dalla paralisi all’infarto, cosa rischi se ti colpisce un fulmine In Italia, la stagione estiva porta con sé non solo ...
Per tutti i ricercatori in erba o per coloro che vogliono vedere al di là delle possibilità dell’occhio umano, è stato sviluppato un incredibile accessorio da applicare ai nostri telefoni cellulari dotati di fotocamera: un vero e proprio microscopio.

I ricercatori della UC Berkeley hanno prodotto questo microscopio per cellulari dotati di fotocamera. Il suo nome è CellScope. Grazie a questo accessorio sarete in grado di fotografare parassiti e batteri a colori evidenziandoli con marcatori fluorescenti.

[adrotate group=”14″ banner=”20″]
Per la realizzazione di CellScope sono stati utilizzati dei filtri per bloccare la luce ambientale e convertire la sorgente luminosa, un semplice LED, in lunghezza d’onda di 460 nanometri per valorizzare il verde della foto. Per gli esperimenti è stata utilizzata una fotocamera da 3,2 megapixel.
Per ora stiamo parlando solo di un prototipo, ma non sarebbe male vedere un genere di gadget sul mercato, sperando ovviamente che il prezzo non sia troppo spropositato.
via [cnet]